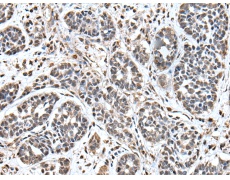
一抗

中文名稱: 兔抗UPK3A多克隆抗體
|
Background: |
This gene encodes a member of the uroplakin family, a group of transmembrane proteins that form complexes on the apical surface of the bladder epithelium. Mutations in this gene may be associated with renal adysplasia. Alternatively spliced transcript variants have been described. |
|
Applications: |
ELISA, IHC |
|
Name of antibody: |
UPK3A |
|
Immunogen: |
Fusion protein of human UPK3A |
|
Full name: |
uroplakin 3A |
|
Synonyms: |
UP3A; UPK3; UPIII; UPIIIA |
|
SwissProt: |
O75631 |
|
ELISA Recommended dilution: |
5000-10000 |
|
IHC positive control: |
Human esophagus cancer |
|
IHC Recommend dilution: |
40-200 |

 購物車
購物車 幫助
幫助
 021-54845833/15800441009
021-54845833/15800441009